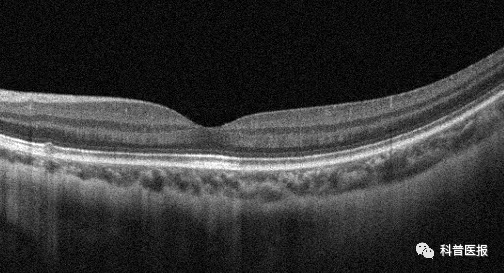
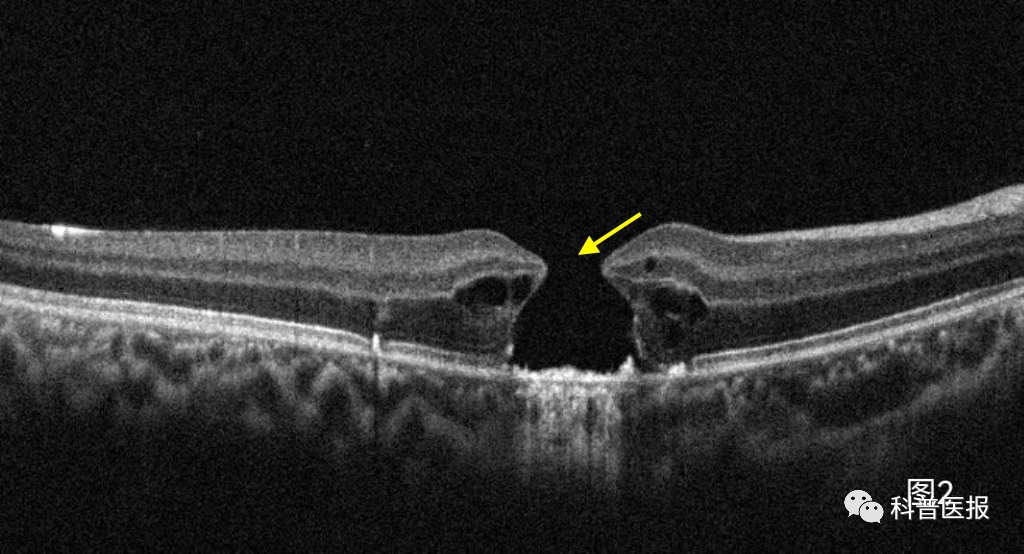

设计制作:王海沣
《放眼视界》

设计制作:李惠斌

切莫将激光笔当玩具

在学校周围的路边摊上经常会遇到这么一个小玩意儿激光笔,它可以发射出漂亮的光线,深受小学生的喜爱,殊不知,在它光鲜的外表下,却能产生巨大的危害,稍不留神,就能导致视力永久性损害。

最近,我接诊了一个叫小温的12岁男孩,发现左眼视力下降,配眼镜时矫正视力只有0.7,所以被介绍到我诊室做进一步检查。详细询问小温情况后得知他除了左眼视物模糊,还伴有眼前中央固定白影遮挡,眼底OCT检查,可见黄斑中心外层组织部分缺损(图1)。详细追问病史得知,小温自己在路边摊偷偷买了激光笔,平时在学校和小朋友们相互照射玩耍,视力下降已有半年多,却一直没敢和父母说,最后小温确诊为左眼光损伤。看完这个小病人,不由得让我想起前一个月门诊还看过一个类似病情的小女孩,甚至一年前还有一个男孩因为激光笔损伤造成一眼黄斑裂孔后来做了手术(图2),遗憾的是术后视力也不能恢复。这些接二连三发生的事情,促使我想和小朋友和家长朋友们说点什么。
正常黄斑中心凹

图1 激光笔照射后导致黄斑中心凹区外层缺失断裂(黄箭头)
图2 激光笔照射后导致黄斑全层裂孔(黄箭头)

激光,就是具有单一波长的光。激光笔,又称为镭射笔、翻页笔、指星笔等,因激光波长不同,所以激光笔可以发出不同颜色的光束市场上出现的大多是红色或橘红色、黄色、绿光等,主要用于学校、科研院所、学术会议等教学或演讲使用。由于激光的热效应,当照射到组织上可以造成损伤。有实验显示,35mw的绿色激光可以穿透塑料布,50mw的绿色激光可以戳爆气球,100mw的绿色激光甚至可以点燃火柴。因此,国家对激光笔的功率有严格的限制,一般为5mw。
如果激光笔照射眼睛,产生的能量很容易造成眼底黄斑区功能损伤,而黄斑位于眼底视网膜中央区,是视力最敏感的区域,黄斑区视网膜色素密集,容易吸收激光的能量,从而受到激光热辐射的伤害。任何累及黄斑部的损害都会引起中心视力的明显下降,视物色暗、变形等,严重情况下可能致盲,通常视网膜光损伤是不可逆性的。

近年来,学校周围的小店时有激光笔出售,但是有很多激光笔未标注激光等级及类型,故存在很大的安全隐患。需要强调的是,即便符合国家标准的激光笔也不能直接照射眼睛。“激光笔伤人”的事情屡见不鲜,但真正了解和关注的人却很少。
所以提醒广大家长和老师,一定要提高警惕,不要让孩子把激光笔当作玩具。如果出现激光笔照射眼睛,一定要第一时间到医院救治,尽量将损害降到最低。

《科普医报》
2023第36期 总第92期
主编:郭述真
监审:柴志凱
常务副主编兼编辑部主任:刘国昇
作者:李双农 周锦秀
科普图片制作:王海沣
副主编兼策划部主任:李惠斌
副主编兼新媒体部主任:王冠麟
副主编兼美编部主任:王海沣


